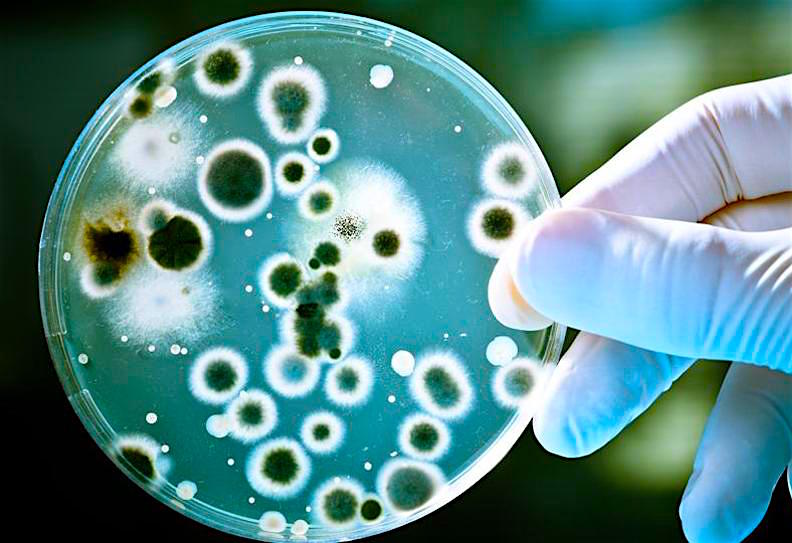
sanificazione virus coronavirus batteri funghi spore

Lo sapevi che, in seguito all’emergenza COVID-19,
il Ministero raccomanda la
sanificazione dei locali?
L’azienda deve assicurare la pulizia giornaliera e la sanificazione periodica dei locali, degli ambienti, delle postazioni di lavoro e delle aree comuni e di svago.
Nel caso di presenza di una persona con COVID-19 all’interno dei locali aziendali, si procede alla pulizia e sanificazione dell’area secondo le disposizioni della circolare n. 5443 del 22 febbraio 2020 del Ministero della Salute, nonché alla ventilazione dei locali.
Va garantita la pulizia a fine turno e la sanificazione periodica di tastiere, schermi touch, mouse, con adeguati detergenti, sia negli uffici, sia nei reparti produttivi.
Nelle aree geografiche a maggiore endemia o nelle aziende in cui si sono registrati casi sospetti di COVID-19, in aggiunta alle normali attività di pulizia, è necessario prevedere, alla riapertura, una sanificazione straordinaria degli ambienti, delle postazioni di lavoro e delle aree comuni, ai sensi della circolare 5443 del 22 febbraio 2020.
Ma come puoi assicurare la corretta
pulizia e sanificazione raccomandata dal Ministero
per te, i tuoi dipendenti ed i tuoi clienti?
Ok! Abbiamo capito che dobbiamo assicurare degli ambienti puliti e sanificati, ma a chi ci rivolgiamo, come facciamo a sapere quali prodotti sono giusti?
In questo periodo ce lo stiamo chiedendo un po’ tutti, la paura di sbagliare e di “non fare la cosa giusta” è alta, oggi più che mai.
Il nostro sistema rappresenta quanto di più all’avanguardia sia disponibile in commercio, in grado di garantire una efficace disinfezione degli ambienti e superfici utilizzando il principio attivo del perossido di idrogeno, unito a ioni di argento che ne catalizzano l’azione.
Da moltissimi anni l’argento e l’acqua ossigenata sono noti per le loro proprietà antibatteriche; la genialità del sistema da noi utilizzato si distingue nel modo in cui vengono utilizzate queste due sostanze, nella semplicità e velocità con la quale è possibile ottenere un risultato eccezionale, e nelle grandi volumetrie che è possibile trattare.
Il tutto è certificato come dispositivo medico.
Molti parlano di disinfezione, ma
hai mai chiesto loro se possono provare il risultato?
In molti casi ciò non succede a causa della scarsa professionalità o della scarsa efficacia dei prodotti utilizzati.
La nostra azienda a richiesta può prelevare dei tamponi per verificare e certificare tramite laboratorio scientifico la carica batterica presente prima e dopo il trattamento con le nostre apparecchiature.
Di cosa si tratta?
Iniziamo stabilendo cosa non è:
NON È UN CLASSICO FUMIGATORE O AEROSOL, apparecchi che creano una sorta di fumo con sostanze di vario tipo.
E’ stato dimostrato che tali sistemi hanno una efficacia limitata; presentano infatti una considerevole tossicità, non hanno una ottimale saturazione del locale da trattare, alcuni lasciano un residuo da rimuovere, e non hanno uno spettro di azione completo.
Si tratta di un erogatore brevettato e di una sostanza liquida a base di perossido di idrogeno (acqua ossigenata) e ioni di argento.
La versatilità del sistema è assoluta, in quanto si deve solo tarare l’erogatore in base ai metri cubi da trattare, schiacciare un pulsante ed uscire dal locale. L’erogatore parte e si ferma automaticamente.
È pratico e lo puoi fare in ogni momento della giornata, secondo le tue necessità, non è necessario chiamare una ditta esterna, ma lo puoi fare in tutta sicurezza e senza problemi, perché verrai istruito da un nostro incaricato quando ti consegnerà il sistema.
L’aspetto interessante e considerevole del sistema è che i batteri non svilupperanno mai una resistenza al trattamento.
Sono interessato ad avere maggiori informazioni,
cosa devo fare?
Compila il modulo seguente:
Lo posso usare anche
nel mio settore?
Ci occupiamo da anni di questi settori, con ottimi risultati, con un unico prodotto andiamo a “sconfiggere” qualsiasi tipo di virus, batterio, spora o fungo:
- asili, scuole pubbliche e private, Università
- Settore estremamente sensibile al rischio di contaminazione da parte di varie patologie a causa della alta affluenza di ragazzi e bambini.
- ospedali, case di cura e dentisti, cliniche private, ambulatori.
- Settore estremamente sensibile al rischio di contaminazione da parte di varie patologie. Sia per gli operatori sanitari come per i pazienti è fondamentale operare ed essere circondati da un ambiente che sia quanto più possibile asettico e sterilizzato. Il contagio può avvenire tramite strumenti, servizi igienici, contatto fisico ed in svariati altri modi. Osmosan, con l’aiuto dei maggiori prodotti sul mercato, si propone di offrire un servizio di disinfezione a 360 gradi in un settore notevolmente importante per il benessere collettivo. Considerati i numerosi protocolli di intervento specifici per la realtà sulla quale si interviene, invitiamo a contattare Osmosan per fissare un sopralluogo ed una consulenza gratuita.
- Hotel, piscine, palestre, cinema e teatro, discoteche e call center
- Industrie alimentari, ristoranti, bed & breakfast, bar, pub, pescherie, panifici
- L’elevato rischio di contaminazioni degli alimenti da parte di agenti chimici, fisici e batteriologici impone il costante intervento presso gli ambienti interessati con operazioni di igiene ambientale ed il realizzarsi di Piani di Autocontrollo redatti seguendo la metodologia indicata dalla normativa 155/97 (H.A.C.C.P.).
- Autobus, ambulanze, treni, aerei, taxi
- L’altissima affluenza presente sui mezzi di trasporto cittadino ci espone ad un notevole rischio di contatti infettivi quotidiani. Basta uno starnuto in un autobus affollato o un contatto con un sedile “ad alto rischio” per poter potenzialmente venir attaccati da agenti batterici. Inoltre, Osmosan propone di effettuare sanificazioni periodiche in ambulanze, considerata la necessità di mantenere queste ultime in condizioni di assoluta asetticità.
- Uffici, appartamenti, negozi, locali privati
- Trattamento UTA ed impianti di canalizzazione aria, fancoils e climatizzatori

I vantaggi
| Il sistema è rapido, basti pensare che in pochi minuti è possibile disinfettare una stanza piena di oggetti, con un risultato impossibile da ottenere operando manualmente. | |
| L’erogatore ed il liquido sono entrambi certificati come dispositivi medici. | |
| Biodegradabile al 99,99%. | |
| E’ privo di qualsiasi tossicità. | |
| Efficace, ed il risultato viene certificato da analisi di laboratorio, a Vostra scelta o con nostro convenzionato. | |
| Il sistema ha uno spettro di azione totale contro ogni tipo di Virus, batterio, spora o fungo. | |
| Può essere utilizzato per gli impianti di climatizzazione contro la legionella o aspergillus. | |
| Il sistema fa sì che i batteri non possano sviluppare resistenza, quindi è efficace nel tempo. | |
| Il sistema non è corrosivo, pertanto macchinari di qualsiasi tipo, computers o quant’altro non verranno minimamente intaccati od ossidati; ciò è garantito e certificato. | |
| La minima persistenza di ioni di argento crea sulle superfici un effetto di tindalizzazione, ossia le superfici saranno refrattarie a futuri insediamenti di colonie batteriche. | |
| Versatilità e semplicità di utilizzo estrema. | |
| Odori presenti nei locali trattati vengono eliminati. |

Ma quanto costa
sanificare i miei locali?
Il costo è più basso di qualsiasi disinfezione fatta in altri modi, ed ha un risultato eccezionale.
Quanto costerebbe avere una ditta esterna per sanificare ogni volta i locali?
Noi ti proponiamo tutto il necessario per sanificare in piena libertà, con prodotti certificati come dispositivi medici, non sono i prodotti che trovi in commercio.
Esiste, inoltre, il BONUS sanificazione del 50%, riconosciuto nella forma di credito d’imposta.
Il credito d’imposta per la sanificazione degli ambienti e degli strumenti di lavoro è rivolto agli esercenti attività d’impresa, arte e professione.
I titolari di partita IVA avranno diritto ad un rimborso del 50% della spesa sostenuta, entro il limite massimo di 20.000 euro per beneficiario.
Richiedi un preventivo:
Compila il modulo seguente:
Il tuo Bonus
Non solo avrai tutto il sistema (erogatore brevettato ed il liquido a base di perossido di idrogeno e ioni di argento) certificato come dispositivo medico, semplice e pratico, da poter usare in ogni momento della giornata, quando vuoi, in piena sicurezza, con la certezza che i batteri non svilupperanno mai una resistenza al trattamento…
MA avrai anche
Assistenza pre e post-vendita GRATUITA, anche per piccole forniture.
INOLTRE, avrai la certezza di poter utilizzare al meglio il sistema, grazie al
Corso di 1 ora, compreso nel prezzo: imparerai ad utilizzare l’erogatore e potrai fare tutte le domande che vorrai al nostro incaricato.
Hai ancora delle domande?
Non ti preoccupare contattaci, saremo lieti di aiutarti:
Fisso +39 031 4475633
Mobile +39 328 0023274
eMail: info@osmosan.it
